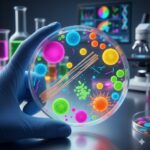
Mikrobiologiske undersøgelser symboliseret ved en petriskål holdt op af en behandsket hånd. Et laboratorielokale i baggrunden.

Mikrobiologiske undersøgelser ved kræft
Resumé om mikrobiologiske undersøgelser
Hvad er mikrobiologiske undersøgelser:
- Mikrobiologiske undersøgelser er laboratorieanalyser, der har til formål at identificere fremmede mikroorganismer i kroppen, såsom bakterier, vira, svampe eller parasitter. Undersøgelserne er afgørende for at diagnosticere og behandle infektioner, som ofte er en alvorlig trussel for personer, der er i kræftbehandling.
Vigtigheden ved kræftforløb:
- Under kemoterapi og strålebehandling bliver immunforsvaret svækket, hvilket øger sårbarheden over for infektioner. Hurtig og præcis identifikation af den inficerende organisme er vital i bestræbelserne på at vælge den korrekte antibiotika- eller svampebehandling for at forhindre, at infektionen udvikler sig livstruende.
Prøvetagning og resultater:
- Prøver tages typisk i form af blodprøver, urinprøver, vævsprøver eller podninger fra sår og slimhinder. Resultatet giver svar på, hvilken organisme der er tale om, og i mange tilfælde også, hvilke lægemidler organismen er følsom over for.
Hvad er mikrobiologiske undersøgelser
Mikrobiologi er den videnskabelige disciplin, der studerer mikroorganismer – levende organismer, der er for små til at blive set med det blotte øje. I klinisk praksis bruges mikrobiologiske undersøgelser til at identificere, isolere og karakterisere mikroorganismer, der forårsager infektioner hos mennesker.
Formålet er at finde ud af, om en person har en infektion, hvilken konkret organisme der er årsag til infektionen, og hvordan den bedst behandles.
Typiske mikroorganismer, der undersøges for:
- Bakterier: F.eks. E. coli eller Staphylococcus aureus.
- Vira: F.eks. Influenza eller cytomegalovirus (CMV).
- Svampe: F.eks. Candida albicans.
Mikrobiologiens rolle i et kræftforløb
For personer i et kræftforløb er mikrobiologiske undersøgelser en af de mest vigtige laboratorieundersøgelser. [1]
Behandlinger som kemoterapi og strålebehandling kan føre til neutropeni (mangel på neutrofile granulocytter, som er en type hvide blodlegemer), hvilket alvorligt svækker immunforsvaret. [3]
I denne tilstand kan selv ellers harmløse bakterier forårsage alvorlige, hurtigt udviklende og livstruende infektioner. Bakteriel infektion er den hyppigste komplikation i forbindelse med kemoterapi-induceret neutropeni [2].
Hurtig diagnose er derfor ikke blot vigtig, men livsnødvendig for at igangsætte den rette behandling, ofte med bredspektret antibiotika, indtil det præcise smitstof er identificeret.
Typer af mikrobiologiske prøver

Prøvematerialet afhænger af den mistænkte infektionskilde.
Dyrkning (kultur)
Dette er den klassiske metode, hvor prøven (f.eks. blod, urin, spinalvæske, væv eller podning) påføres et dyrkningsmedie (f.eks. en petriskål) og placeres i en varm inkubator (varmeskab). Hvis der er levedygtige mikroorganismer i prøven, vil de formere sig over 1-2 døgn og danne kolonier, som patologen kan identificere og undersøge nærmere.
- Anvendelse: Diagnostik af bakterie- og svampeinfektioner.
- Eksempler: Urindyrkning (for urinvejsinfektion), sårpodning (for fremmed vækst).
Følsomhedstest (resistensbestemmelse)
Når en bakterie- svampe- eller virus koloni er identificeret, er det vigtigt at vide, hvilke antibiotika der faktisk er effektive mod disse. Det gøres med en følsomhedstest, hvor eksempelvis bakterien udsættes for forskellige antibiotika. Testen afgør, om bakterien er følsom over for et lægemiddel (hvilket betyder, at det vil virke), eller om den er resistent (hvilket betyder, at lægemidlet ikke vil have effekt).
- Vigtighed: Dette er afgørende for at undgå at spilde tid på ineffektiv behandling, især ved alvorlige infektioner hos immunkompromitterede.
Molekylær diagnostik (PCR)
Polymerase Chain Reaction (PCR) er en moderne og meget hurtig metode, der ikke kræver dyrkning. PCR-teknikken opformerer små mængder af mikroorganismens DNA eller RNA i prøven, så den kan identificeres.
- Fordel: Giver ofte svar inden for timer, ikke dage.
- Anvendelse: Benyttes hovedsageligt til at påvise vira (f.eks. COVID-19, CMV) eller bakterier, der er vanskelige at dyrke.
Mikroskopi og farvning
Prøven kan også analyseres direkte under et mikroskop efter en farvningsprocedure (f.eks. Gramfarvning for bakterier). Dette giver et hurtigt, men dog kun foreløbigt, svar om typen af organisme (f.eks. stavformede eller runde bakterier) og dermed et fingerpeg om hvilke medikamenter der vil være virksomme.
Risici ved infektioner for kræftramte

For personer med kræft – især dem i intensiv behandling – er infektioner forbundet med betydelige risici, som ikke må bagatelliseres.
Febril neutropeni
Febril neutropeni er den mest alvorlige infektionsrelaterede komplikation under kemoterapi. Det er en tilstand, hvor man udvikler feber samtidigt med, at antallet af neutrofile granulocytter er meget lavt. [3]
- Konsekvens: Uden neutrofiler (soldaterne i immunforsvaret) kan kroppen ikke bekæmpe infektionen. En infektion, der normalt er mild, kan udvikle sig til blodforgiftning (sepsis) på få timer. [2]
- Håndtering: Ved tegn på feber i forbindelse med eller umiddelbart efter kemoterapi skal man øjeblikkeligt søge læge. Lægen vil starte behandling med bredspektret antibiotika med det samme – før mikrobiologiens resultater foreligger – for at dække de mest sandsynlige bakterier.
Andre infektioner
Svampe- og virusinfektioner er også hyppige og alvorlige. Svampeinfektioner (f.eks. Candida) er særligt alvorlige og svære at behandle, hvis de spreder sig til blodet.
Se også Svamp – lokalt/hele kroppen
Tolkning af resultater

Resultaterne fra mikrobiologiske undersøgelser er afgørende for at igangsætte den korrekte behandling, men de skal altid tolkes i patientens kliniske kontekst.
Normal flora vs. infektion
Mange mikroorganismer lever naturligt på huden, i tarmen og på slimhinderne (normalflora). Hvis en prøve tages fra et sted, der har kontakt med normalflora (f.eks. en podning fra et sår), kan det være svært at skelne mellem de uskadelige koloniserende (herboende) bakterier og de bakterier, der faktisk forårsager infektionen. Lægen og mikrobiologen skal vurdere, om mængden og typen af fund stemmer overens med patientens symptomer. Et fund i blodet er derimod næsten altid tegn på alvorlig infektion.
Resistens er afgørende
Det vigtigste resultat er følsomheds-testen (resistens bestemmelsen). Dette svar er en afgørende faktor for lægen, da det direkte påvirker valget af antibiotika. Hvis mikroorganismen er resistent over for det antibiotikum, man er startet med, skal behandlingen straks skiftes for at forhindre, at infektionen udvikler sig kritisk. Du skal altid spørge lægen, om følsomhedstesten har ført til en justering af din medicin.
Resultatkategorier og hyppige fund

Når prøven er analyseret i laboratoriet, falder resultatet typisk i én af tre overordnede kategorier, men det specifikke fund er altid vigtigst:
- Positivt resultat: Der er fundet én eller flere specifikke mikroorganismer (bakterier, virus eller svamp). Dette resultat bekræfter infektionen og udløser øjeblikkelig følsomhedstest for at vælge den rigtige medicin.
- Negativt resultat: Der er ikke fundet sygdomsfremkaldende mikroorganismer. Hvis symptomerne fortsætter, vil lægen tage nye prøver.
- Uspecifikt (inkonklusivt) resultat: Prøven var utilstrækkelig eller forurenet med almindelige hudbakterier, hvilket gør en præcis vurdering umulig. Dette kræver altid en ny prøve.
Hyppigst fundne organismer i et kræftforløb
De mest almindelige positive fund i en mikrobiologisk undersøgelse, er ofte relateret til bakterier, der lever naturligt i kroppen, men som bliver farlige, når immunforsvaret svækkes:
Gramnegative stave (f.eks. E. coli):
- En hyppig årsag til urinvejsinfektioner og sepsis (blodforgiftning). E. coli lever normalt i tarmen, men kan være livstruende, hvis denne bakterie spreder sig.
Stafylokokker (f.eks. staphylococcus epidermidis):
- Ses ofte ved kateterrelaterede infektioner, hvis man har et PICC-line eller en port. Dette er hudbakterier, der trænger ind i blodbanen via indstiksstedet.
Se også Port-a-Cath
Gærsvamp (candida albicans):
- Den hyppigste årsag til svampeinfektioner i munden og på slimhinder efter kemoterapi (trøske). Kan i alvorlige tilfælde give infektion i blodbanen.
Atypiske bakterier:
- Visse bakterier som f.eks. Clostridium difficile kan give alvorlig diarré i forbindelse med antibiotikabehandling, og påvises via afføringsprøver.
Se også Svamp – lokalt/hele kroppen
Konklusion

Mikrobiologiske undersøgelser er helt afgørende i kræftbehandlingen, især i perioder med neutropeni, hvor infektioner udgør en reel og øjeblikkelig risiko.
Prøver og følsomhedstests giver lægerne mulighed for hurtigt at identificere smitstoffet og målrette behandlingen, hvilket er kritisk for at forhindre alvorlige og livstruende komplikationer.
Viden om de mikrobiologiske risici og hurtig handling ved feber er det bedste forsvar for den kræftramte.
Links
[1] Mikrobiologisk prøvetagning – en oversigt (Sundhed.dk, 2025)
- Indhold: En generel, faglig beskrivelse af, hvad mikrobiologiske undersøgelser omfatter, herunder dyrkning, følsomhedstest og påvisning af mikroorganismer.
[2] Hurtig identifikation af patienter med neutropeni og feber forbedrer prognosen (Ugeskriftet.dk, 2015)
- Indhold: En videnskabelig artikel der understreger, at bakteriel infektion er den hyppigste komplikation ved kemoterapi-induceret neutropeni. Artiklen belyser, hvor vigtig hurtig mikrobiologisk dokumentation er for behandlingen.
[3] Neutropeni (Sundhed.dk, Lægehåndbogen, 2024)
- Indhold: En faglig beskrivelse af tilstanden neutropeni og den akut behandlingskrævende tilstand febril neutropeni, herunder vigtigheden af hurtig opstart af bredspektret antibiotika.
Siden er oprettet:
d. 27.11.25
❤
Hvad du læser på Jeg har Kræft er ikke en anbefaling. Søg kompetent vejledning.
Forfatterinfo og professionelt grundlag

Samtlige artikler på dette site er udarbejdet og valideret af undertegnede, Hanne Kjær Uhlig. Jeg er uddannet sygeplejerske (1975, med klinisk erfaring frem til 2013) og cand.arch. (1983, med speciale i industriel design), samt underviser i en årrække på DTU (Danmarks Tekniske Universitet).
Efter tabet af min mor til kræft i 2000 og min egen kræftdiagnose i 2024, stiftede jeg dette non-profit informationssite Jeg har Kræft.
Målet er at bruge min analytiske og akademiske systematik til at bringe overblik, sikkerhed og videnskabelig dokumentation ind i feltet for integrativ, komplementær og alternativ kræftbehandling. Samtidig benyttes min sundhedsfaglige erfaring til at gøre artikler patientnære – og vedkommende.
Artiklens kendetegn:
- Klinisk og personlig ballast: Skabt ud fra en kombination af årtiers erfaring som sygeplejerske og egne oplevelser som patient og pårørende.
- Videnskabelig systematik: Indholdet bygger på systematisk research af medicinske databaser samt kliniske forsøg. Artiklerne er konsekvent underbygget med kildehenvisninger under Links.
- Uafhængigt non-profit projekt: Driften sikres via frivillige bidrag og medlemskaber gennem Støtteforeningen Jeg har Kræft. Sitet er fuldstændig uafhængigt af kommercielle producentinteresser og arbejder udelukkende for at fremme kræftramtes livskvalitet.
- Støtteforeningens bestyrelse består af:
- Formand: Hanne Kjær Uhlig , sygeplejerske og cand.arch.
- Kasserer: Jens Ottosen-Støtt, jurist
- Medlem: Thomas Kjær Uhlig, speciallæge, øjensygdomme
- Medlem: Martin Kjær Uhlig, cand.merc.aud.
Fællesskab: Bliv medlem af Facebookgruppen: Jeg har Kræft – Hvad kan jeg gøre?
❤
Hvad du læser på Jeg har Kræft er ikke en anbefaling. Søg kompetent vejledning.

